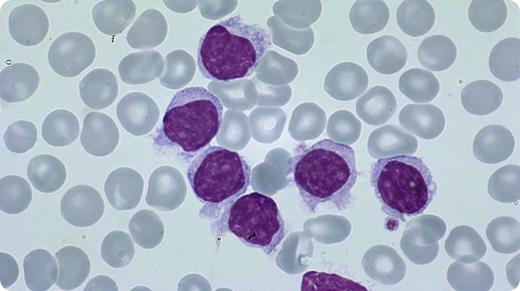
An 81-year-old man was evaluated for a leucocytosis (76 G/L) with 90% atypical lymphocytes and mild thrombocytopenia (130 G/L). The atypical lymphocytes were large, with round or oval nuclei, condensed chromatin, often a prominent nucleolus, and a blue-grayish cytoplasm with scattered hairy projections, often resembling prolymphocytes. By flow cytometry, hairy cell leukemia-variant (HCL-v) was diagnosed (CD19+/CD11c+/CD103+/CD25−). According to the World Health Organization 2008 classification, HCL-v has to be distinguished from 2 other B-cell neoplasms, which may present as hairy leukemias: HCL and splenic marginal zone lymphoma (SMZL). The distinction between HCL and HCL-v is clinically important, because HCL-v responds poorly to nucleosid analogues, which is the standard treatment for HCL. / HCL typically features a pancytopenia (particularly monocytopenia), whereas HCL-v usually shows a considerable leucocytosis, with many prolymphocytic elements, which are rare in HCL. A dry tap is typical for HCL due to marrow fibrosis, but aspiration is usually possible in HCL-v. The flow cytometric detection of 4 antigens (CD11c/CD25/CD103/CD123) allows the correct diagnosis: HCL and HCL-v are positive for CD11c, CD103, and CD123, whereas CD103 and CD123 are negative in SMZL. CD25 is positive in HCL and negative in HCL-v. The BRAF-V600E mutation, typical for HCL, is not found in HCL-v.

An 81-year-old man was evaluated for a leucocytosis (76 G/L) with 90% atypical lymphocytes and mild thrombocytopenia (130 G/L). The atypical lymphocytes were large, with round or oval nuclei, condensed chromatin, often a prominent nucleolus, and a blue-grayish cytoplasm with scattered hairy projections, often resembling prolymphocytes. By flow cytometry, hairy cell leukemia-variant (HCL-v) was diagnosed (CD19+/CD11c+/CD103+/CD25−). According to the World Health Organization 2008 classification, HCL-v has to be distinguished from 2 other B-cell neoplasms, which may present as hairy leukemias: HCL and splenic marginal zone lymphoma (SMZL). The distinction between HCL and HCL-v is clinically important, because HCL-v responds poorly to nucleosid analogues, which is the standard treatment for HCL.
HCL typically features a pancytopenia (particularly monocytopenia), whereas HCL-v usually shows a considerable leucocytosis, with many prolymphocytic elements, which are rare in HCL. A dry tap is typical for HCL due to marrow fibrosis, but aspiration is usually possible in HCL-v. The flow cytometric detection of 4 antigens (CD11c/CD25/CD103/CD123) allows the correct diagnosis: HCL and HCL-v are positive for CD11c, CD103, and CD123, whereas CD103 and CD123 are negative in SMZL. CD25 is positive in HCL and negative in HCL-v. The BRAF-V600E mutation, typical for HCL, is not found in HCL-v.
An 81-year-old man was evaluated for a leucocytosis (76 G/L) with 90% atypical lymphocytes and mild thrombocytopenia (130 G/L). The atypical lymphocytes were large, with round or oval nuclei, condensed chromatin, often a prominent nucleolus, and a blue-grayish cytoplasm with scattered hairy projections, often resembling prolymphocytes. By flow cytometry, hairy cell leukemia-variant (HCL-v) was diagnosed (CD19+/CD11c+/CD103+/CD25−). According to the World Health Organization 2008 classification, HCL-v has to be distinguished from 2 other B-cell neoplasms, which may present as hairy leukemias: HCL and splenic marginal zone lymphoma (SMZL). The distinction between HCL and HCL-v is clinically important, because HCL-v responds poorly to nucleosid analogues, which is the standard treatment for HCL.
HCL typically features a pancytopenia (particularly monocytopenia), whereas HCL-v usually shows a considerable leucocytosis, with many prolymphocytic elements, which are rare in HCL. A dry tap is typical for HCL due to marrow fibrosis, but aspiration is usually possible in HCL-v. The flow cytometric detection of 4 antigens (CD11c/CD25/CD103/CD123) allows the correct diagnosis: HCL and HCL-v are positive for CD11c, CD103, and CD123, whereas CD103 and CD123 are negative in SMZL. CD25 is positive in HCL and negative in HCL-v. The BRAF-V600E mutation, typical for HCL, is not found in HCL-v.
For additional images, visit the ASH IMAGE BANK, a reference and teaching tool that is continually updated with new atlas and case study images. For more information visit http://imagebank.hematology.org.

This feature is available to Subscribers Only
Sign In or Create an Account Close Modal